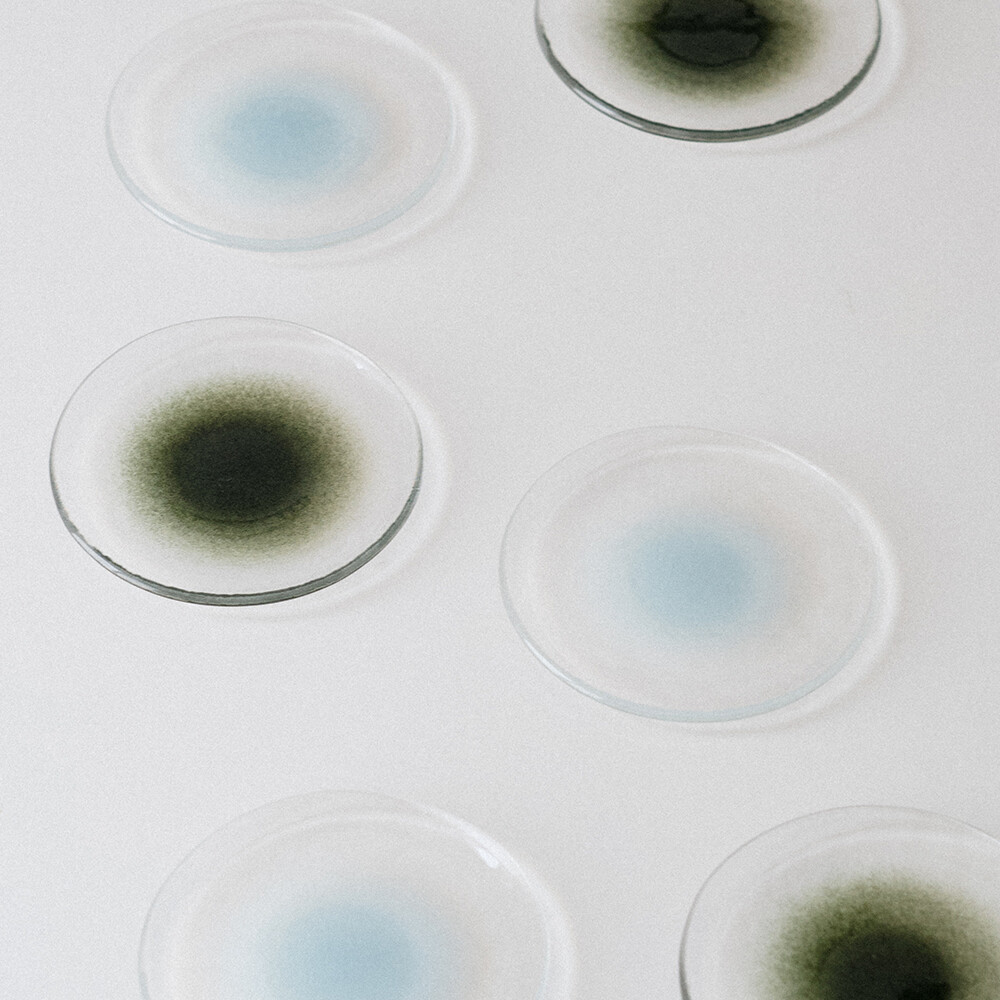

굿모닝제너럴스토어


굿모닝제너럴스토어

*굿모닝 제너럴 스토어의 이미지, 그래픽 및 기타 제작물은 지식 재산권을 포함한 저작권을 소유하고 있으며, 저작권법의 보호를 받습니다. 동의 없는 무단 복제 및 무단 도용은 민, 형사상의 처벌 대상입니다.
DELIVERY (배송 안내)
배송비
· 주문 금액 6만원 이상: 무료 배송
· 주문 금액 6만원 미만: 배송비 3,300원 부과
· 도서·산간·제주 등 일부 지역은 항공료·도선료 등 추가 비용이 발생할 수 있습니다.
배송 기간
· 결제 완료일로부터 영업일 기준 1~3일 이내 출고됩니다.
· 단, 재고 상황이나 택배사 사정에 따라 다소 지연될 수 있으며, 이 경우 별도 안내드립니다.
반송
· 수취인 부재, 연락처/주소 오류 등으로 반송되는 경우 왕복 배송비는 구매자가 부담합니다.
· 단, 판매자 귀책(오배송·상품 불량 등)으로 인한 반송은 판매자가 비용을 부담합니다.
EXCHANGE & RETURNS (교환 및 환불 안내)
반품 주소지: (02837)서울시 성북구 성북로108 301호 / 굿모닝제너럴스토어
신청 및 기한
· 상품 수령일로부터 7일 이내 교환 및 환불(청약철회)이 가능합니다.
· 상품이 표시·광고 내용과 다르거나 계약과 다르게 이행된 경우에는 수령일로부터 3개월 이내, 또는 그 사실을 안 날로부터 30일 이내에 교환 및 환불을 신청할 수 있습니다.
· 청약철회 의사표시는 Q&A 게시판, 고객센터, 이메일 등으로 접수 가능하며, 접수일 기준으로 효력이 발생합니다.
비용 부담
· 단순 변심: 왕복 배송비는 소비자 부담 (예: 소재나 마감 취향 등)
· 상품 불량, 오배송, 표시·광고와 상이한 경우: 왕복 배송비 전액 판매자 부담
· 그 외 별도의 위약금, 포장비, 취소수수료 등은 청구하지 않습니다.
반품 시 유의사항
· 상품은 수령 당시와 동일한 상태로 재포장해 주셔야 합니다. (택, 라벨, 포장 박스, 증정품 등 구성품 포함)
· 파손 위험이 있는 상품(도자기, 유리, 전자제품 등)은 완충재를 사용해 안전하게 포장해 주세요.
· 소비자의 부주의로 인한 포장 불량으로 발생한 파손은 환불이 제한될 수 있습니다.
· 파손 우려가 있는 상품은 발송 전 포장 상태를 사진이나 영상으로 기록해 두시면, 추후 사고 발생 시 참고 자료로 활용할 수 있습니다.
교환·환불이 불가능한 경우
· 청약철회 가능 기간을 경과한 경우
· 소비자 책임으로 상품이 훼손되거나 사용 흔적이 있는 경우 (세탁, 오염, 심한 구김, 착용 흔적 등)
· 상품의 가치가 훼손되어 재판매가 불가능한 경우 (밀봉 개봉 상품, 포장 훼손 등)
· 구성품(택, 박스, 증정품 등)이 훼손·누락된 경우
· 소비자 주문에 따라 개별 제작된 상품(단, 사전 고지 및 동의가 있는 경우에 한함)
불량 여부 판단 기준
· 상품 불량 여부는 판매자에서 상품 회수 후 직접 검수하여 최종 판단합니다.
· 고객의 주관적인 불만족(예: 소재나 마감 취향 등)은 불량 사유로 인정되지 않을 수 있으며, 이 경우 단순 변심으로 처리됩니다.
환불 절차 및 시점
· 반품 상품이 도착한 날로부터 3영업일 이내 환불을 진행합니다.
NOTICE
1. 유리 제품 구입 전 안내사항
유리 제품 제조 공정(블로잉, 몰드 성형 등)의 특성상 아래와 같은 현상들이 나타날 수 있으며, 이는 제품의 불량이 아닌 자연스러운 현상이므로 교환 및 반품 사유가 될 수 없음을 미리 안내드립니다. 구매 전 반드시 숙지하시어 신중한 선택을 부탁드립니다.
2. 유리 제품 취급주의 안내
구매하신 유리 제품을 오랫동안 안전하게 사용하시기 위해 아래의 취급 주의사항을 꼭 지켜주시기 바랍니다.
궁금한 점이 있으실 경우 Q&A 게시판에 남겨주시면 확인 후 빠르게 답변드리겠습니다.
| 번호 | 제목 | 글쓴이 | 등록일 |
| 작성된 질문이 없습니다. |
하루유리 물든 플레이트 Blue